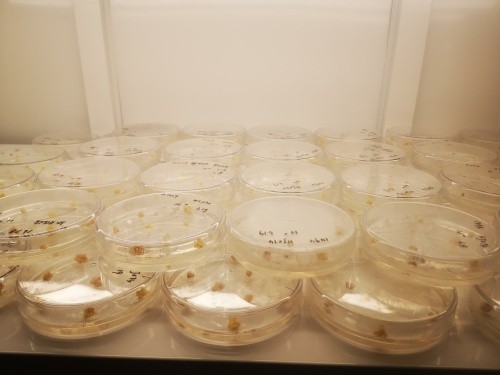

近日,位于武漢國家現(xiàn)代農業(yè)產業(yè)科技創(chuàng)新中心核心功能區(qū)高農生物園的武漢艾迪晶生物科技有限公司收到了期盼已久的國家高新技術企業(yè)認證證書。國家高新技術企業(yè)認證是對在國家重點支持的高新技術領域內,持續(xù)進行科技開發(fā)與技術成果轉化研究,形成企業(yè)核心自主知識產權,并以此為基礎開展生產經(jīng)營活動的企業(yè)的認可。該認證旨在培育行業(yè)新技術和新業(yè)態(tài),促進經(jīng)濟升級發(fā)展,是對企業(yè)科研實力及科研水平的有力證明。

武漢艾迪晶生物科技有限公司依托院士團隊開發(fā)的多基因疊加技術和多基因編輯技術,建有智能化精準育種系統(tǒng)、高通量基因編輯、高通量植物遺傳轉化、檢測和分析、田間試驗基地等平臺。
“如果把生物的基因組比作一句話,基因編輯就像是對這句話當中的某些詞匯進行精減、潤色等修飾,并不引入新的基因?!蔽錆h艾迪晶生物科技有限公司總經(jīng)理凌永國介紹到,公司憑借多基因疊加技術和多基因編輯技術可以一次性對多個基因進行操作,非常高效、精準。
如果說種子是農業(yè)的芯片,基因編輯便是生物育種所必需的光刻機。今年1月,農業(yè)農村部制定公布了《農業(yè)用基因編輯植物安全評價指南(試行)》,進一步規(guī)范農業(yè)基因編輯植物的安全評價管理,促進我國生物育種技術和產業(yè)發(fā)展。

基因編輯能為作物育種做些什么?“基因編輯是一種精準而靈活的技術,可使育種者對植物基因組特定目標性狀進行編輯改進。比如,編輯香蕉的乙烯合成基因,成功使香蕉采后的乙烯釋放量降低了90%,香蕉的儲藏期也從22天延長到80多天”凌永國著重談到“編輯三個以上基因,可能要好多年才能拿到結果,但是利用我們的技術,可以一次性的把多個基因同時編輯,就相當于一個單基因編輯的時間,極大地節(jié)約了研發(fā)時間”。
2022年中央一號文件中提出,要大力推進種源等農業(yè)關鍵核心技術攻關。如何打好種業(yè)翻身仗,培育出高產、優(yōu)質、抗病的農作物品種,是擺在艾迪晶生物等生物育種企業(yè)面前的一道道課題。作為生命科學領域的革命性技術,基因編輯技術將帶動農作物育種進入“精準調控時代”?;蚓庉嫾夹g的發(fā)展,尤其是多基因疊加技術和多基因編輯技術以及配套分析軟件平臺,必將成為打好種業(yè)翻身仗、帶動種業(yè)發(fā)展的新引擎,也是提升種業(yè)競爭力的利器。
艾迪晶生物主打的“大數(shù)據(jù)+基因編輯”精準靶向育種平臺涵蓋分子生物學平臺、植物遺傳轉化平臺、檢測分析平臺、基因數(shù)據(jù)庫、田間試驗基地五個部分,解決了分子育種中復雜性狀的多基因聚合和多基因編輯與結果分析等“卡脖子”技術問題。“我們同時也在開展共性技術研究,供各種不同作物使用,從而達到分子育種高效精準的目的。”凌永國表示,通過應用該平臺,創(chuàng)制了多個功能營養(yǎng)型水稻新種質和一批重要農藝性狀改良系以及水稻遠緣雜種親和系,其中擁有自主知識產權陸稻抗除草劑性狀的成功創(chuàng)制,在國內尚屬首例。
“目前國內外共有800多個實驗室使用這個平臺,軟件訪問量達到了130萬次。”在多種作物和植物中培育出大量新型遺傳材料和新種質,為生物技術精準育種提供了高效的通用技術。如:創(chuàng)制高油酸大豆,油酸含量從本地材料20%提高到編輯后的材料約80%;創(chuàng)制無豆腥味大豆,可用于加工生產無豆腥味蛋白制品;創(chuàng)制了矮化突變體,實現(xiàn)了玉米株高降低,有利于玉米抗倒伏和耐密植;選育的水稻新品種“吳稻1號”米質好,抗特定除草劑。
艾迪晶生物已在湖北鄂州、海南三亞、云南西雙版納、山東曲阜等地建立了標準化的種苗種植基地,四季各時段均可解決種苗種植問題。據(jù)悉,該公司已申請及授權“一種批量快速檢測DNA序列突變的方法”等發(fā)明專利及實用新型專利等17項、植物新品種權4項,先后獲得科技“小巨人”企業(yè)、優(yōu)質高端創(chuàng)業(yè)項目、“3551”創(chuàng)業(yè)人才等榮譽。(通訊員 張燦)
轉自:中國經(jīng)濟時報網(wǎng)
【版權及免責聲明】凡本網(wǎng)所屬版權作品,轉載時須獲得授權并注明來源“中國產業(yè)經(jīng)濟信息網(wǎng)”,違者本網(wǎng)將保留追究其相關法律責任的權力。凡轉載文章及企業(yè)宣傳資訊,僅代表作者個人觀點,不代表本網(wǎng)觀點和立場。版權事宜請聯(lián)系:010-65363056。
延伸閱讀